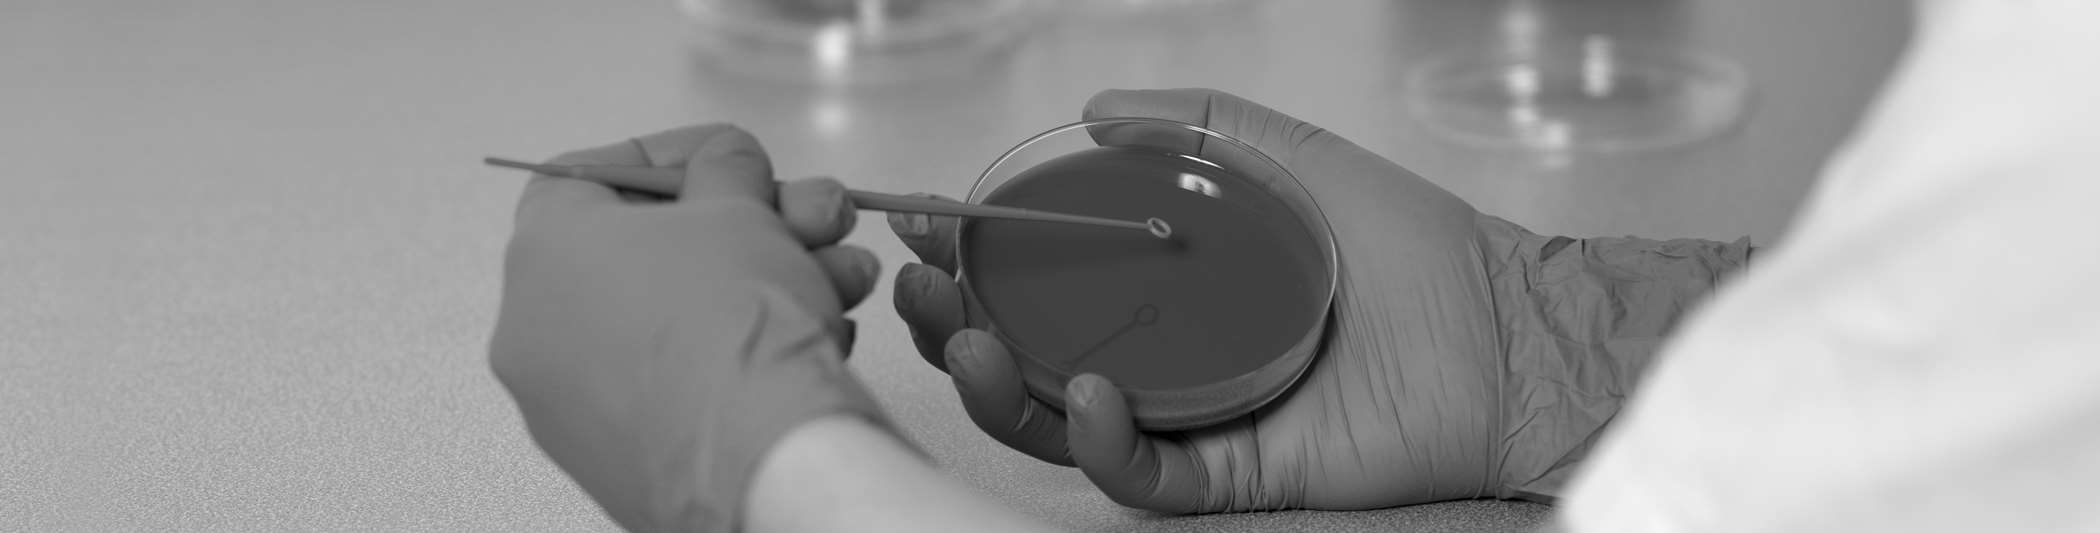
graphic
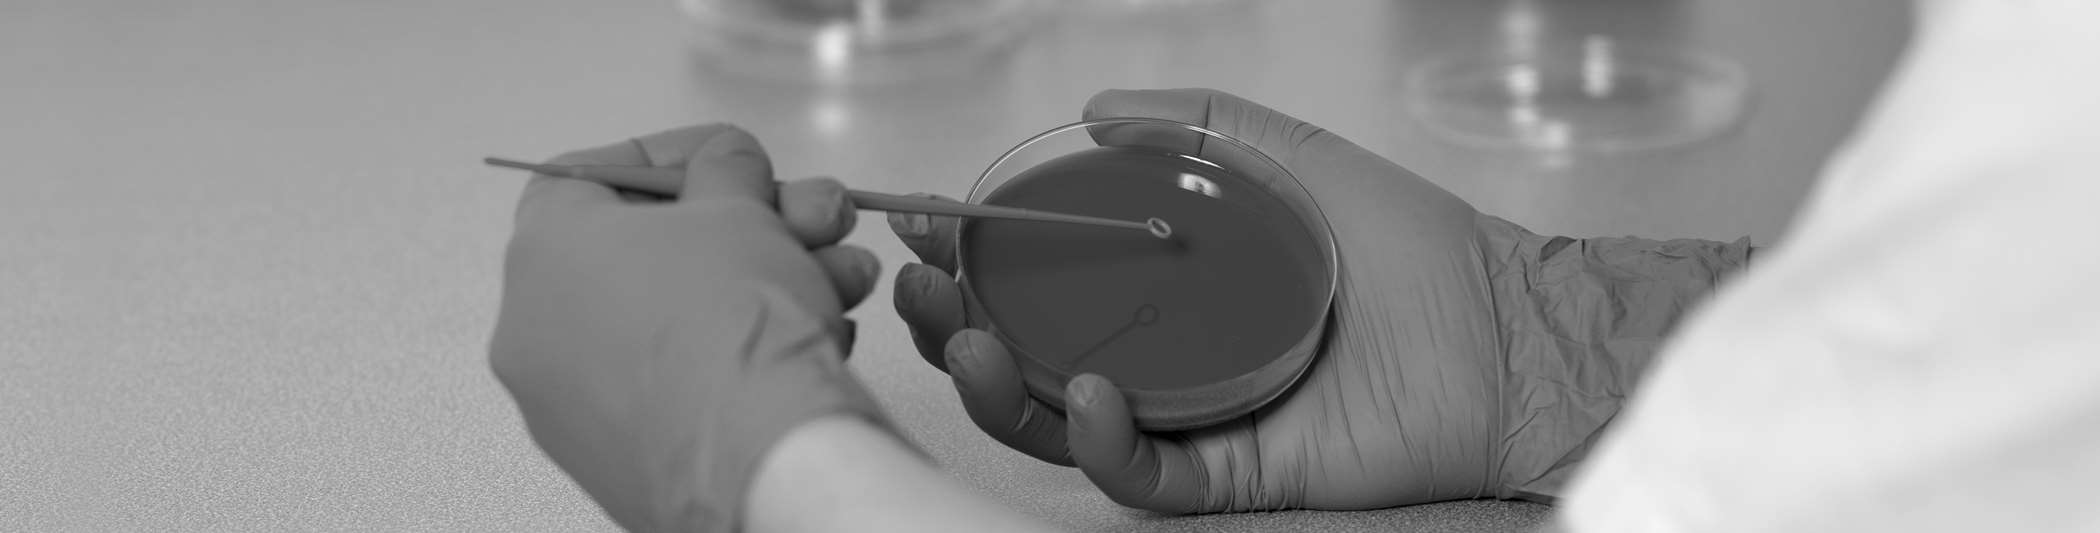
graphic

Kennzahlen
Patienten
Im stationären Bereich verzeichnete die SRFT 7'655 verrechenbare Patientenaustritte. Dies entspricht einer Erhöhung um 4.9% gegenüber dem Vorjahr, in welchem die Zahl der stationären Patienten pandemiebedingt stark zurückging. Auch die ambulanten Besuche sind mit plus 9.0% gegenüber dem Vorjahr wieder angestiegen.
7'655
Stationäre Patientenaustritte
80'127
Ambulante Besuche
Personal
Der Personalaufwand beläuft sich insgesamt auf CHF 68.8 Mio. Er sinkt um 3.3% und liegt damit um CHF 2.3 Mio. tiefer als im Vorjahr. Nach Abzug der Rückstellung für den Sozialplan des Personals wegen der vorzeitigen Schliessung des Spitals Wattwil beträgt der Rückgang gar CHF 4.6. Mio. Begründet sind diese tieferen Personalkosten hauptsächlich darin, dass die Mitarbeitenden der Rettung St. Gallen per 01.01.2021 im Kantonsspital St.Gallen angestellt wurden.
590
Mitarbeitende (Vollzeitstellen)
95
davon Auszubildende
Ausserordentlich hoher Verlust
Das Geschäftsjahr 2021 schliesst die Spitalregion Fürstenland Toggenburg mit einem ausserordentlich hohen Verlust von rund CHF 61.7 Mio. In diesem Ergebnis sind die Wertberichtigung für die Immobilien in Wattwil in der Höhe von CHF 51.8 Mio. sowie weitere unmittelbare Sondereffekte aufgrund der Schliessung des Spitals Wattwil von CHF 2.6 Mio. enthalten. Ohne die genannten Sondereffekte würde ein Verlust von CHF 7.3 Mio. und somit ein um CHF 2.7 Mio. besseres betriebliches Ergebnis als im Vorjahr resultieren. Die EBITDA-Marge reduziert sich gegenüber 2020 von -3.6% auf -3.7%.
102.3 Mio.
Umsatz in CHF
-61.7 Mio.
Jahresergebnis in CHF
-3.7%
EBITDA

Felix H. Sennhauser,
Prof. Dr. med. em.
Verwaltungsratspräsident
2021 – ein Jahr mit speziellen Herausforderungen

René Fiechter,
mag. oec. HSG
CEO der Spitalregion Fürstenland Toggenburg
Das Jahr der Klarheit
Highlights 2021

Deutlich mehr Patienten auf der Notfallstation Wil
Die Zahl der Patientinnen und Patienten, welche sich auf der Notfallstation Wil behandeln lassen, stieg nach der Schliessung des Spitals Flawil im Sommer 2021 deutlich an.

Leitungsübergabe in der Schmerzambulanz
Ende 2021 wird der Leitende Arzt Wolfgang Schreiner nach 18 Jahren in der SRFT pensioniert. Er übergibt die Leitung der Schmerzambulanz an Dr. med. Marianne Korfmann.
Hervorragendes Zertifizierungsergebnis
Qualitätsexperten der Stiftung SanaCERT Suisse haben im Herbst 2021 die Qualitätsarbeit in der SRFT am Standort Wil intensiv geprüft und das mit einem hervorragenden Resultat.

Geburtshilfe: Neues Angebot – neuer Chefarzt
Mit der hebammengeleiteten Geburt hat die Klinik für Gynäkologie und Geburtshilfe im Spital Wil ihr geburtshilfliches Angebot erweitert. Ein neuer Chefarzt wurde auf April 2022 gewählt.

Schliessung des Spitals Wattwil per Ende März 2022
Um eine unkontrollierte Schliessung zu verhindern, hat der Verwaltungsrat im August entschieden, das Spital Wattwil bereits spätestens per März 2022 zu schliessen.

Onkologie im Spital Wil verstärkt
Durch eine fix für das Spital Wil zuständige ärztliche Leitung konnte die Kontinuität in der Betreuung erhöht und der Austausch innerhalb des Netzwerks vereinfacht werden.

Mit Herz und Kompetenz
Mit den beiden Spitälern Wil und Wattwil (bis Ende März 2022) stellt die Spitalregion Fürstenland Toggenburg gemeinsam mit den niedergelassenen Ärztinnen und Ärzten die medizinische Versorgung in der Region sicher.